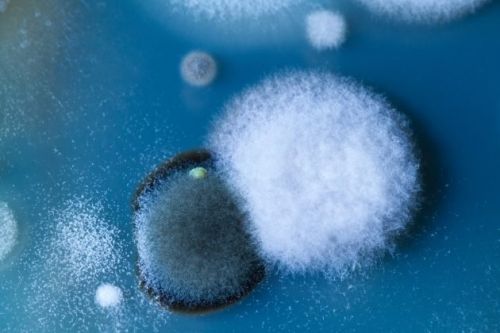

Чем опасна новогодняя елка в доме
Кара Вада, иммунолог-аллерголог из Университета штата Огайо, предостерегает, что совсем скоро многие люди столкнутся с таким состоянием, как «синдром новогодней елки».
Оказывается, на поверхности этих деревьев содержится около 50 видов плесени, среди которой аллергены, провоцирующие кашель, хрипоту, насморк, головную боль, покраснение глаз, дерматиты и проблемы с дыханием.
Данный синдром – это совокупность аллергических реакций, которые вызывает сок, пыльца и плесень хвойных деревьев.
«Дерево может выделять раздражающий сок, который опасен тем, что способен вызывать серьезную сыпь. Кроме того, пыльца ели является основным аллергеном», - говорит профессор Кара Вада. Врачи уверены, что в большинстве случаев аллергия проявляется в основном незначительными симптомами, но иногда бывают такие реакции организма, которые заканчиваются даже пневмонией. Это связано с тем, что 70 % елей заражены грибком, который при воздействии тепла распыляется в воздух.
«Синдром новогодней елки» могут усугубить химические препараты, которыми обрабатываю деревья, чтобы придать им товарный вид или избавиться от вредителей.
Серьезно задуматься об этой проблеме должны курильщики, аллергики и люди, больные бронхиальной астмой. Но даже если все члены семьи здоровы, дольше недели держать ель в доме не рекомендуется.
Комментарии